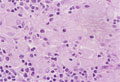

- 22.Pediatric pathology
- (7)Congenital metabolic disease (Gaucher disease)
Microscopic view, high power, (H&E); In the absence of beta-glucocerebrosidase, glucocerebroside cannot be catalytically converted into ceramide and glucose and thus it accumulated in histiocytes (lysosome).These histiocytes take on a large vacuolated appearance and are termed Gaucher cells. These are seen in bone marrow, liver, spleen and lymph node with striated cytoplasm (often described as resembling wrinkled tissue paper)
Click the image to see the enlarged image.